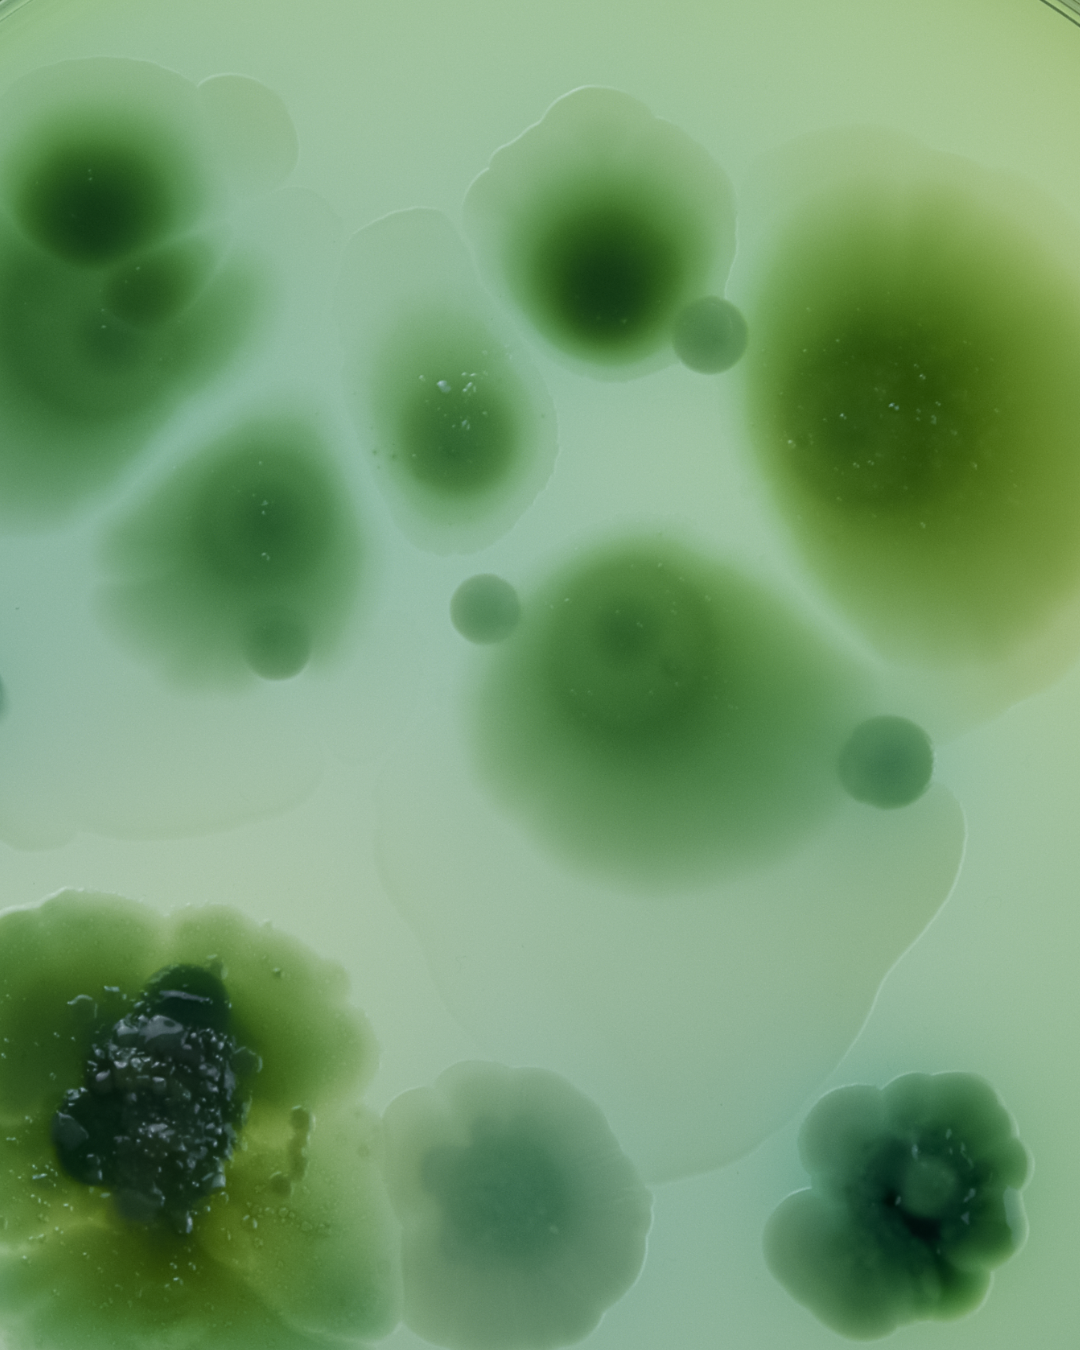
Je voedt je lichaam — maar voed je ook je darmbacteriën?

Je voedt je lichaam — maar voed je ook je darmbacteriën?
Je eet gezond. Je beweegt. Je drinkt genoeg water. Je let op je slaap. En toch — iets voelt niet helemaal goed. Wisselende stoelgang. Een opgeblazen gevoel dat maar niet weggaat. Minder energie dan je zou verwachten.
Je doet alles wat de richtlijnen zeggen. Maar er is één ding dat de meeste mensen vergeten: je darmbacteriën voeden.
Maar het probleem zit dieper. Je microbioom — de biljoenen micro-organismen in je darmen — bepaalt veel meer dan je denkt. En als die bacteriën niet krijgen wat ze nodigJoey Bruggeman hebben, merk je dat overal in je lichaam.

Je Microbioom: Het Onzichtbare Orgaan
Je darmen bevatten meer bacteriën dan je lichaam cellen heeft. Samen vormen ze je microbioom — een ecosysteem dat invloed heeft op bijna elk aspect van je gezondheid:
1. Energieniveau
Je darmbacteriën spelen een directe rol in hoe efficiënt je lichaam energie haalt uit voedsel. Een verstoord microbioom betekent minder efficiënte stofwisseling — en dat voel je als vermoeidheid en een gebrek aan uithoudingsvermogen.
2. Immuunsysteem
70% van je immuunsysteem zit in je darmwand. Je darmbacteriën trainen je afweercellen en produceren stoffen die je weerstand reguleren. Uit balans? Dan ben je vatbaarder voor alles wat rondgaat.
3. Stemming & mentale helderheid
Je darmen produceren meer dan 90% van je serotonine — de neurotransmitter die je humeur reguleert. Een ongezonde darmflora kan leiden tot prikkelbaarheid, brain fog en een algeheel gevoel van onbehagen.
4. Huidgezondheid
De gut-skin axis is geen trend — het is biologie. Een verstoorde darmflora leidt tot meer ontstekingen, wat zich uit in een doffe teint, onzuiverheden en huidproblemen.
Waarom Een Probioticum Niet Genoeg Is
Veel vrouwen grijpen naar een probioticum wanneer ze darmklachten hebben. En hoewel probiotica nuttig kunnen zijn, missen ze een cruciaal element: voeding voor de bacteriën die er al zijn.
Probiotica voegen nieuwe bacteriën toe. Maar die overleven alleen als ze voedsel krijgen — en als de omgeving in je darmen hen ondersteunt.
Prebiotica zijn dat voedsel. Het zijn onverteerbare vezels die selectief de goede bacteriën voeden die al in je darmen leven. Zonder prebiotica heeft een probioticum weinig blijvend effect.
De ideale aanpak: je bestaande darmflora voeden met prebiotische vezels, aangevuld met verteringsenzymen en micronutriënten die je darmomgeving optimaliseren.
Het verschil? Probiotica zijn als zaadjes planten in droge grond. Prebiotica zijn de regen die de grond vruchtbaar maakt.

Wat Je Darmflora Écht Nodig Heeft
Een gezond microbioom heeft drie dingen nodig: het juiste voedsel, een goede vertering en bescherming tegen oxidatieve stress.
Prebiotische vezels
Inuline, acaciavezel en guarvezel zijn drie van de best onderzochte prebiotische vezels. Ze worden niet verteerd in je maag, maar fermenteren in je dikke darm — precies waar je goede bacteriën ze nodig hebben. Het resultaat: meer diversiteit, een sterkere darmbarrière en een betere stoelgang.
Verteringsenzymen
Verteringsenzymen helpen eiwitten sneller af te breken, waardoor je darmen minder belast worden. Een efficiëntere vertering betekent minder fermentatie van onverteerd voedsel — en dus minder gas, opgeblazen gevoel en ongemak.
Antioxidanten & micronutriënten
Spirulina en chlorella leveren chlorofyl, fycocyanine en essentiële aminozuren die je darmcellen beschermen. Vitamine C, zink en magnesium ondersteunen de herstelfunctie van je darmwand.
Daily Greens+: Voeding Voor Je Microbioom
Daily Greens+ van Vitasonar is ontwikkeld om je darmflora te voeden met wat het écht nodig heeft — geen losse probiotica, maar een complete formule die je microbioom van binnenuit ondersteunt. Eén schep per dag, citrus-bessensmaak.
Prebiotisch Vezelcomplex: Inuline, Acacia & Guar
Drie complementaire prebiotische vezels die op verschillende plaatsen in je dikke darm fermenteren. Dit zorgt voor een bredere voeding van je darmbacteriën — meer diversiteit, meer korteketenvetzuren, een sterkere darmbarrière.
Verteringscomplex
Natuurlijke enzymen die eiwitten efficiënt afbreken. Minder belasting voor je darmen, minder onverteerd voedsel, minder gasvorming. Een rustiger en comfortabeler spijsverteringsstelsel.
Micronutriëntcomplex: Spirulina, Chlorella & Acerola
Spirulina en chlorella leveren antioxidanten en essentiële aminozuren. Acerola biedt natuurlijke vitamine C. Aangevuld met zink en magnesium — alles wat je darmcellen nodig hebben om gezond te blijven.
Wat je kunt verwachten
Je darmflora herstellen is een geleidelijk proces. Maar de eerste signalen van verbetering merk je snel:
1
Comfortabelere vertering
De enzymen werken direct. Je voelt je minder opgeblazen na maaltijden. Je stoelgang wordt regelmatiger.
2-3
Darmflora komt in balans
De prebiotische vezels voeden je goede bacteriën. Je merkt meer comfort, minder gasvorming en een stabielere vertering.
4-6
Brede gezondheidsverbetering
Meer energie, betere weerstand, een helderdere huid. De effecten van een gezond microbioom worden zichtbaar in je hele lichaam.


Probeer Daily Greens+
De complete greens-blend die je darmflora voedt met prebiotische vezels, enzymen en micronutriënten — in één schep.
- 3 soorten prebiotische vezels voor je darmflora
- Verteringsenzymen voor vlotte vertering
- Spirulina + chlorella voor antioxidanten
- Vitamine C, zink & magnesium
- Citrus-bessensmaak, makkelijk dagelijks ritueel